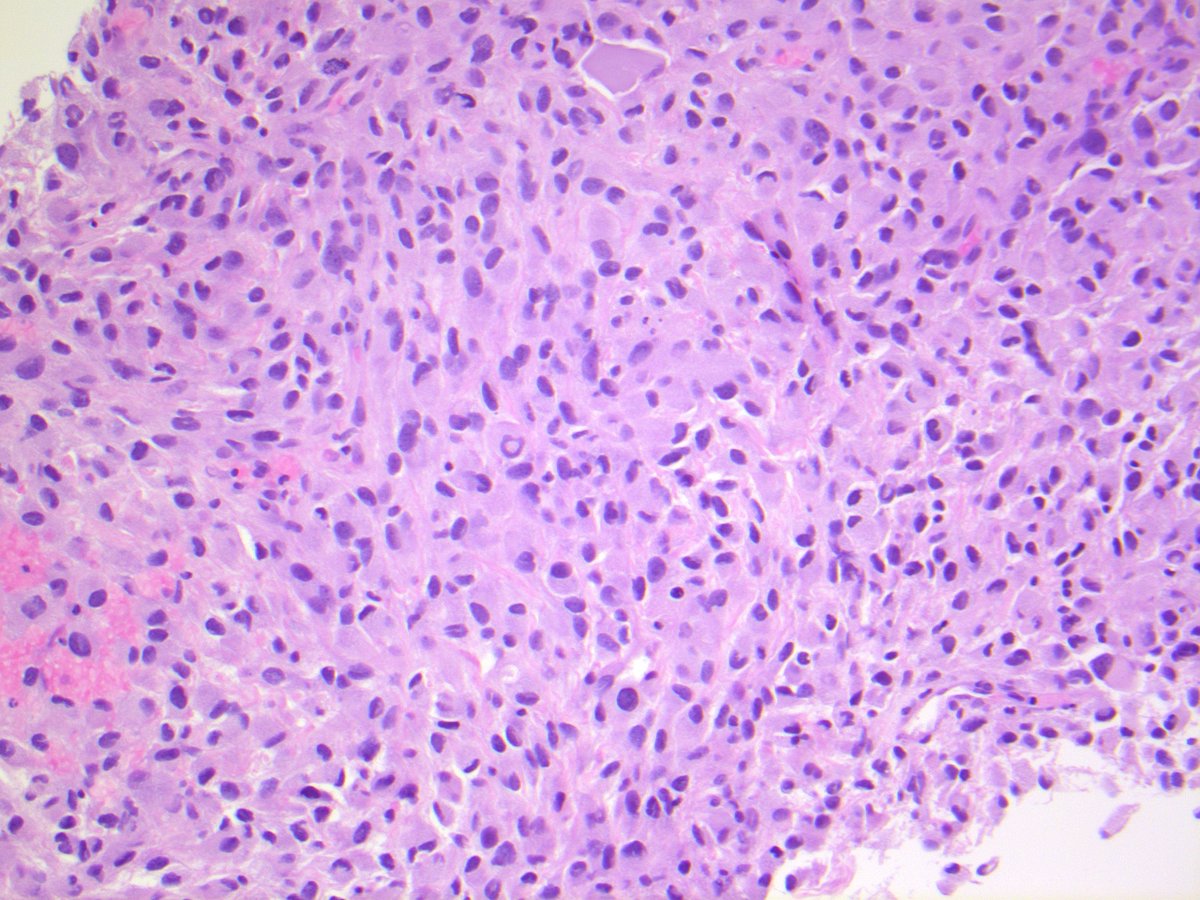
UNDIFFERENTIATED PLEOMORPHIC SARCOMA. NB: no identifiable line of differentiation by IHC; sheets of polygonal-epithelioid cells; abundant eosinophilic cytoplasm; marked nuclear pleomorphism, with multinucleation and conspicuous mitotic activity; necrosis.
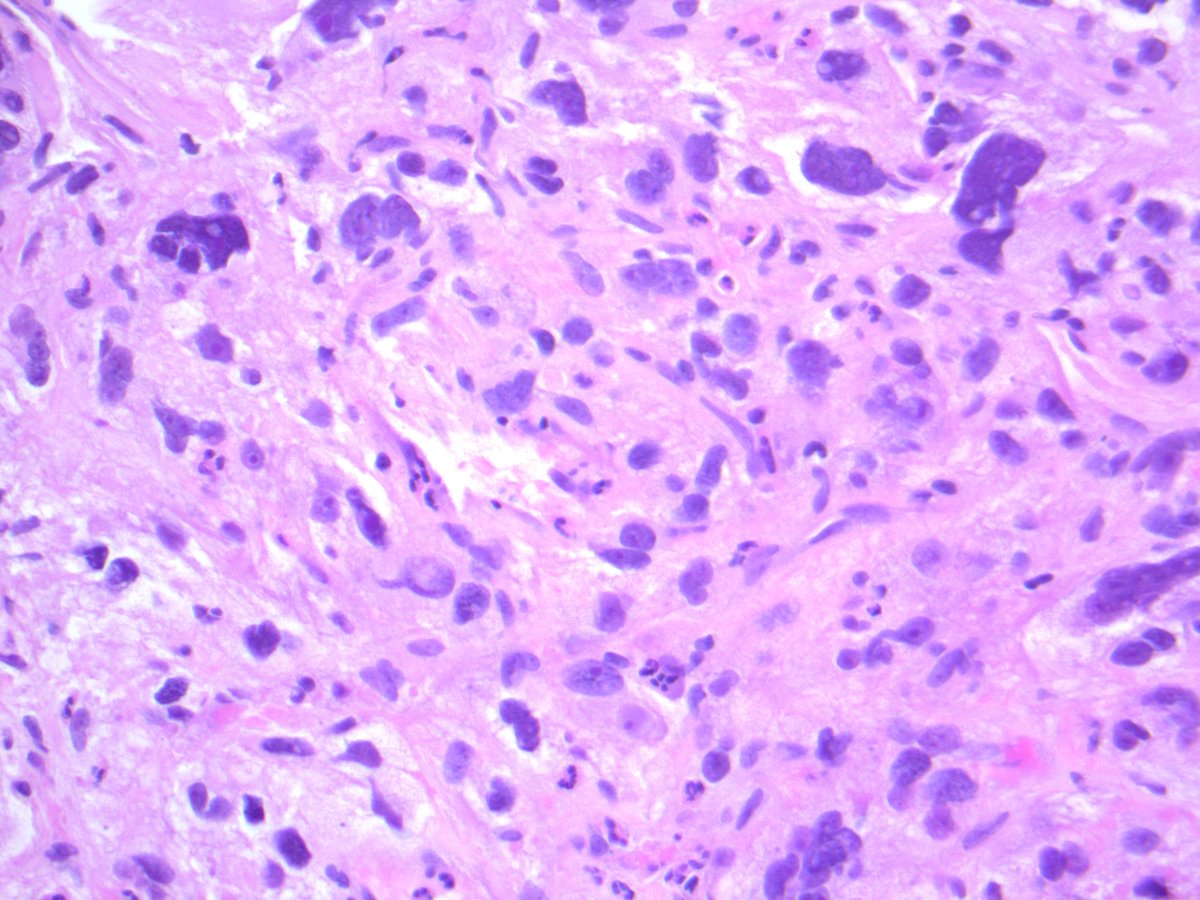
UNDIFFERENTIATED PLEOMORPHIC SARCOMA. NB: no identifiable line of differentiation by IHC; sheets of polygonal-epithelioid cells; abundant eosinophilic cytoplasm; marked nuclear pleomorphism, with multinucleation and conspicuous mitotic activity; necrosis.
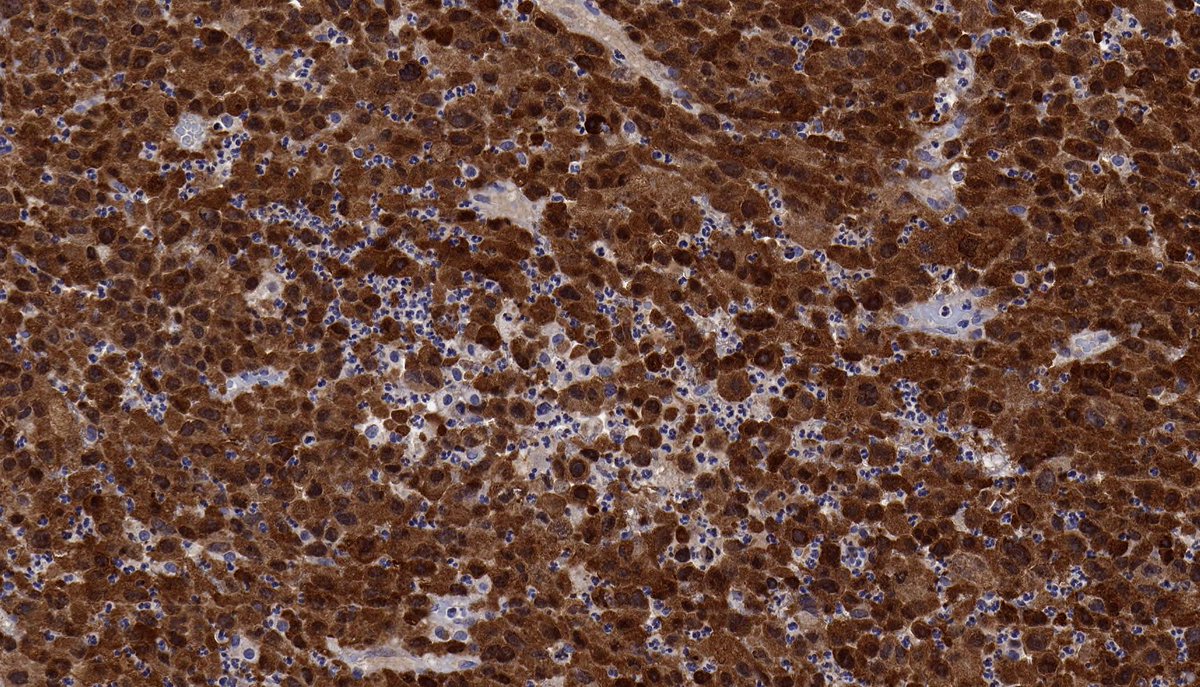
In this neoplasm IHC was diffusely positive for MDM2 and CDK4, and FISH confirmed the presence of MDM2 amplification. The findings support classification as DEDIFFERENTIATED LIPOSARCOMA (epithelioid variant). PMID: 28719466, 29307627.
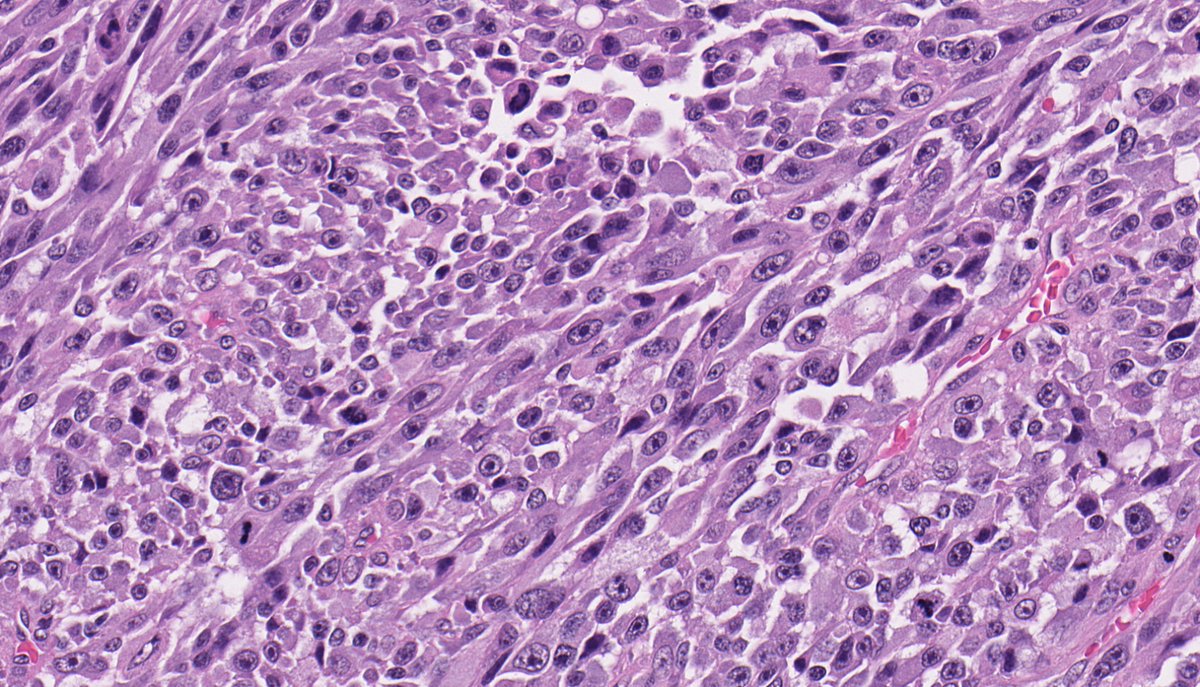
In addition to a UPS-like morphology (FISH: + MDM2 amplification), dedifferentiated liposarcoma is known for a wide range of distinctive variants, including:

UNKNOWNS (2020.07.17). Elderly male; rapidly enlarging thigh mass; IHC: (-) desmin, smooth muscle actin, S100, CD34, & panCK
Diagnosis?
Epithelioid-spindle cells arranged in sheets-fascicles. Abundant amphophilic cytoplasm. Round-ovoid nuclei with pleomorphism, macronucleoli & brisk mitotic activity. Interspersed neutrophils. Necrosis is conspicuous. A basic spindle cell panel was non-contributory. DDx:
CLEAR CELL SARCOMA. NGS: EWSR1-ATF1. NB: fascicles and nests of spindle-epithelioid cells; eosinophilic-amphophilic cytoplasm; monomorphic nuclei with macronucleoli and rare mitotic activity; thin fibrous septa, wreath-like multinucleated giant cells and melanin pigment.
MYXOFIBROSARCOMA (epithelioid variant). NB: cellular fascicles of spindle cells & small cohesive clusters of epithelioid cells in abundant myxoid stroma; abundant eosinophilic cytoplasm; ovoid-round nuclei, with pleomorphism and conspicuous mitotic activity. (PMID: 17197925).
UNDIFFERENTIATED PLEOMORPHIC SARCOMA. NB: no identifiable line of differentiation by IHC; sheets of polygonal-epithelioid cells; abundant eosinophilic cytoplasm; marked nuclear pleomorphism, with multinucleation and conspicuous mitotic activity; necrosis.
OTHER:
The morphology and immunophenotype are non-specific, and there is a broad differential for the findings. An algorithmic morphologic based approach is helpful for guiding the differential. Cases such as this often require multiple rounds of IHC...
The morphology and immunophenotype are non-specific, and there is a broad differential for the findings. An algorithmic morphologic based approach is helpful for guiding the differential. Cases such as this often require multiple rounds of IHC...
It is also important to consider the clinical context, including common tumours in this location. In addition to UPS and MFS, a relatively common sarcoma in this location is liposarcoma....
In this neoplasm IHC was diffusely positive for MDM2 and CDK4, and FISH confirmed the presence of MDM2 amplification. The findings support classification as DEDIFFERENTIATED LIPOSARCOMA (epithelioid variant). PMID: 28719466, 29307627.
In addition to a UPS-like morphology (FISH: + MDM2 amplification), dedifferentiated liposarcoma is known for a wide range of distinctive variants, including:
DEDIFFERENTIATED LIPOSARCOMA (myxofibrosarcoma-like variant). (FISH: + MDM2 amplification.) PMID: 10584701, 15832195, 23020289.
DEDIFFERENTIATED LIPOSARCOMA (with so-called 'low-grade' dedifferentiation). (FISH: + MDM2 amplification.) PMID: 9060596, 9127316.
DEDIFFERENTIATED LIPOSARCOMA (with meningothelial-like whorls and metaplastic bone formation). (FISH: + MDM2 amplification.) PMID: 9839165, 21317707.
DEDIFFERENTIATED LIPOSARCOMA (with inflammation, incl. leukemoid reaction). (FISH: + MDM2 amplification.) PMID: 9311018, 11391379.

 Read on Twitter
Read on Twitter

![DEDIFFERENTIATED LIPOSARCOMA (with "homologous" lipoblastic [pleomorphic liposarcoma-like] differentiation). (FISH: + MDM2 amplification.) PMID: 20588177. DEDIFFERENTIATED LIPOSARCOMA (with "homologous" lipoblastic [pleomorphic liposarcoma-like] differentiation). (FISH: + MDM2 amplification.) PMID: 20588177.](https://pbs.twimg.com/media/EdJ3Ab-XoAEtIRq.jpg)
![DEDIFFERENTIATED LIPOSARCOMA (with "homologous" lipoblastic [pleomorphic liposarcoma-like] differentiation). (FISH: + MDM2 amplification.) PMID: 20588177. DEDIFFERENTIATED LIPOSARCOMA (with "homologous" lipoblastic [pleomorphic liposarcoma-like] differentiation). (FISH: + MDM2 amplification.) PMID: 20588177.](https://pbs.twimg.com/media/EdJ3BwIXoAAbRF2.jpg)


